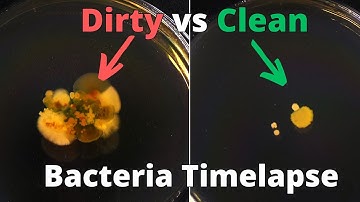
What Grows On Your Hands? Washed vs Unwashed in Bacteria Timelapse

⬇ DOWNLOAD NOW
Kalau muncul iklan pop-up, tutup lalu klik tombol kembali
Download lagu These Simple Ingredients Trigger Microbial Revival _ LAZY BUT VERY EFFECTIVE! secara gratis hanya untuk keperluan promosi. Dukung artis favorit kamu dengan membeli musik original di iTunes atau platform resmi lainnya.
 From Soil to Self: The Microbes That Heal Us from the Ground Up
From Soil to Self: The Microbes That Heal Us from the Ground Up
What Grows On Your Hands? Washed vs Unwashed in Bacteria Timelapse
What Grows On Your Hands? Washed vs Unwashed in Bacteria Timelapse
 Bacteria 3D Animation
Bacteria 3D Animation
 The Evolution of Bacteria on a “Mega-Plate” Petri Dish (Kishony Lab)
The Evolution of Bacteria on a “Mega-Plate” Petri Dish (Kishony Lab)
 Your Very Special Bacterial Cloud
Your Very Special Bacterial Cloud
 The beneficial bacteria that make delicious food - Erez Garty
The beneficial bacteria that make delicious food - Erez Garty
 These 5 Microbes Could Change Your Health
These 5 Microbes Could Change Your Health
 The Dirtiest Things In Your House (You'll Be Surprised!) | Bacteria Experiment
The Dirtiest Things In Your House (You'll Be Surprised!) | Bacteria Experiment